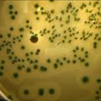
Cómo prevenir la listeriosis

Llega el verano y con la subida de las temperaturas, el riesgo de sufrir las temidas intoxicaciones alimentarias se disparan al favorecerse el desarrollo de toxinas y microorganismos. La mayoría de las bacterias transmitidas por los alimentos crecen más rápido a temperaturas superiores a los 30º. Ello unido a la humedad, más propia en verano, favorecen su proliferación.
Una circunstancia que se une a otra. En verano, aumentan las actividades y comidas al aire libre, comemos más fuera de casa y la conservación, almacenamiento, refrigeración y lavado de los alimentos no siempre se realiza de manera correcta, poniendo en riesgo nuestra salud.
Llegan infecciones como la salmonelosis y la hepatitis A, o intoxicaciones, como el botulismo y la gastroenteritis por enterotoxina estafilocócico, que suelen aumentar de forma en el periodo estival.
De hecho, pese a los controles, la Comunidad de Madrid registró en 2023 un récord de casos asociados a brotes epidémicos de origen alimentario, hasta alcanzar los 2.118 afectados, principalmente relacionados con establecimientos de restauración (49,4%).
La salmonella generó el mayor número de brotes con 49 de 85 (57,6%) y también más hospitalizaciones (48 de 50), mientras que la bacteria Clostridium perfringens fue la causante del mayor número de casos, 439, casi la mitad de los casos confirmados.
Los alimentos elaborados con pollo han sido los más frecuentemente confirmados por laboratorio: 5 brotes con presencia de aminas biógenas y otros 2 por C. perfringens.
La limpieza deficiente en utensilios y superficies, temperaturas de conservación en frío no adecuadas, y contaminación cruzada entre productos han sido los condicionantes más frecuentes en los brotes colectivos.
Por ello ello puede resulta de utilidad recordar algunos conceptos básicos. Ante todo, no olvidemos que la contaminación microbiana, incluso elevada, no tiene por qué manifestarse en el deterioro perceptible del alimento. La apariencia, no basta.
Las Reglas de Oro
La Agencia Española de Seguridad Alimentaria y Nutrición recomienda la observación de las siguientes normas, basadas en las llamadas “Reglas de Oro” para la preparación higiénica de los alimentos de la Organización Mundial de la Salud.
1.-Consumir alimentos que hayan sido tratados o manipulados higiénicamente.
No se debe consumir leche cruda sin tratamiento térmico previo.
Las carnes, pescados y productos de repostería deben estar refrigerados o congelados.
En los establecimientos de restauración es obligatorio el empleo de ovoproductos en la elaboración de platos a base de huevo crudo en los que no se alcancen al menos 70 °C durante dos segundos en el centro del producto o 63 °C durante veinte segundos en el centro del producto si se sirve para su consumo inmediato.
Si preparas estos alimentos en casa, debes consumirlos inmediatamente, no aprovechar las sobras y, de no consumir de inmediato, conservarlos en frio.
El lavado de los huevos no está recomendado, pero si lavas los huevos antes de utilizarlos porque estén muy sucios, debes hacerlo inmediatamente antes de su uso.2. Cocinar correctamente las carnes
Los alimentos pueden estar contaminados por microorganismos, los cuales pueden ser destruidos por el calor. La temperatura a la que debe someterse el alimento debe ser suficiente para que este alcance un mínimo de 70 °C en el centro del producto, al menos durante 2 minutos.
3. Consumir los alimentos inmediatamente después de ser cocinados.Evita dejar los alimentos cocinados a temperatura ambiente. Es la mejor manera de que no proliferen los gérmenes.
4. Conservar correctamente los alimentos cocinados.
Los alimentos que no puedan ser consumidos inmediatamente o las sobras que se quieran guardar, deben mantenerse bajo la acción del calor, por encima de 60 °C, o del frío, a 5 °C como máximo.
5. Prevenir anisakiasis
Con el fin de prevenir la anisakiasis, si vas a preparar en casa pescado crudo o poco cocinado (preparaciones culinarias como los boquerones en vinagre), hazlo después de haberlo mantenido congelado durante cinco días a una temperatura de -20 °C o inferior.
6. Calentar suficientemente los alimentos cocinados.Para conservarlos después de su preparación, puedes mantener caliente hasta su consumo aquellos alimentos que lo permitan (sopas, purés, guisos...).
7. Refrigeración de las sobras
Otro tipo de alimentos que no puedan ser sometidos a calor (ensaladas, gazpachos, etc.), deben ser refrigerados inmediatamente. Las sobras de comidas deben refrigerarse lo antes posible, no debiendo estar más de 2 horas a temperatura ambiente.
8. Evitar el contacto entre los alimentos crudos y los cocinados.
Un alimento cocinado puede volver a contaminarse por contacto con los alimentos crudos o con objetos que anteriormente hayan contactado con un alimento crudo (cuchillos, tablas, superficies, trapos, etc.).El trapo de cocina o la bayeta puede ser un excelente vehículo de contaminación. Es preferible usar papel de cocina.
9. Higiene y limpieza
Asegurar una correcta higiene de la persona que va a manipular los alimentos y una limpieza adecuada en todas las superficies de la cocina.
El trapo de cocina o la bayeta puede ser un excelente vehículo de contaminación. Es preferible usar papel de cocina.
La persona que manipule alimentos, debe observar unas estrictas prácticas higiénicas. Es imprescindible que tenga las manos siempre limpias, que se las lave cada vez que haga falta y siempre que haga uso del servicio.
Las superficies donde se manipulan los alimentos (tablas de cortar, encimeras), así como los utensilios de cocina, deben mantenerse limpios. Se debe tener especial cuidado en almacenar la basura en recipientes lisos, lavables y cerrados y que estos no se encuentren cerca de los alimentos.
10. Mantener los alimentos fuera del alcance de insectos, roedores y animales de compañía.
No hay que olvidar que los animales pueden ser portadores de gérmenes patógenos y parásitos que originan enfermedades de transmisión alimentaria.
11. No consumir alimentos perecederos que estén expuestos a temperatura ambiente.
En bares, cafeterías, restaurantes, etc., todos los alimentos perecederos deben estar protegidos por vitrinas y conservados en condiciones sanitarias adecuadas. Deben estar refrigerados siempre que sea preciso. Estas medidas deben ser exigidas por el consumidor, y cuando se observe que no se cumplen, los alimentos deben ser rechazados.